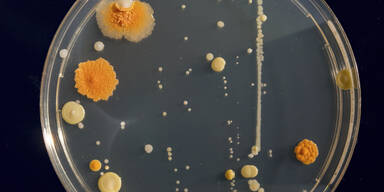
pilz

Weltweit breitet sich ein gefährlicher Hefe-Pilz aus, der Infizierten gefährlich wird - schlimmstenfalls sogar zum Tod führen kann.
Erstmals 2009 in Japan entdeckt, sorgt der Hefepilz Candida auris seit Jahren weltweit für Schlagzeilen. Der Erreger gilt als besonders gefährlich für bereits geschwächte Patientinnen und Patienten und kann gegen viele Medikamente resistent sein.
Um eine Ausbreitung zu verhindern, werden vor allem Risikopatienten getestet. Die US-Gesundheitsbehörde CDC schätzt, dass zwischen 30 und 60 Prozent der Betroffenen sterben, wenn der Pilz in den Körper eindringt. Besonders problematisch: Candida auris ist resistent gegen verschiedene Medikamente und kann schwere Infektionen verursachen.
Schwierige Eindämmung
Das ECDC (Europäisches Zentrum für die Prävention und Kontrolle von Krankheiten) warnt, dass der Erreger lange auf Oberflächen und medizinischen Geräten überleben kann. Er wird über sogenannte Schmierinfektionen von Mensch zu Mensch übertragen. Eine Ausbreitung über die Luft – wie beim Coronavirus – findet dagegen nicht statt.
DAS sind die Symptome
Allein in Deutschland wurden im vergangenen Jahr 120 Fälle registriert. „Ich würde sogar so weit gehen, zu sagen, dass gehandelt werden muss, wenn man einen einzigen Fall hat“, sagte Tim Eckmanns vom Robert-Koch-Institut der „Bild“. Symptome sind laut der Zeitung zu Beginn Fieber und Schüttelfrost, später können Harnwege, Ohren oder Atemwege betroffen sein.